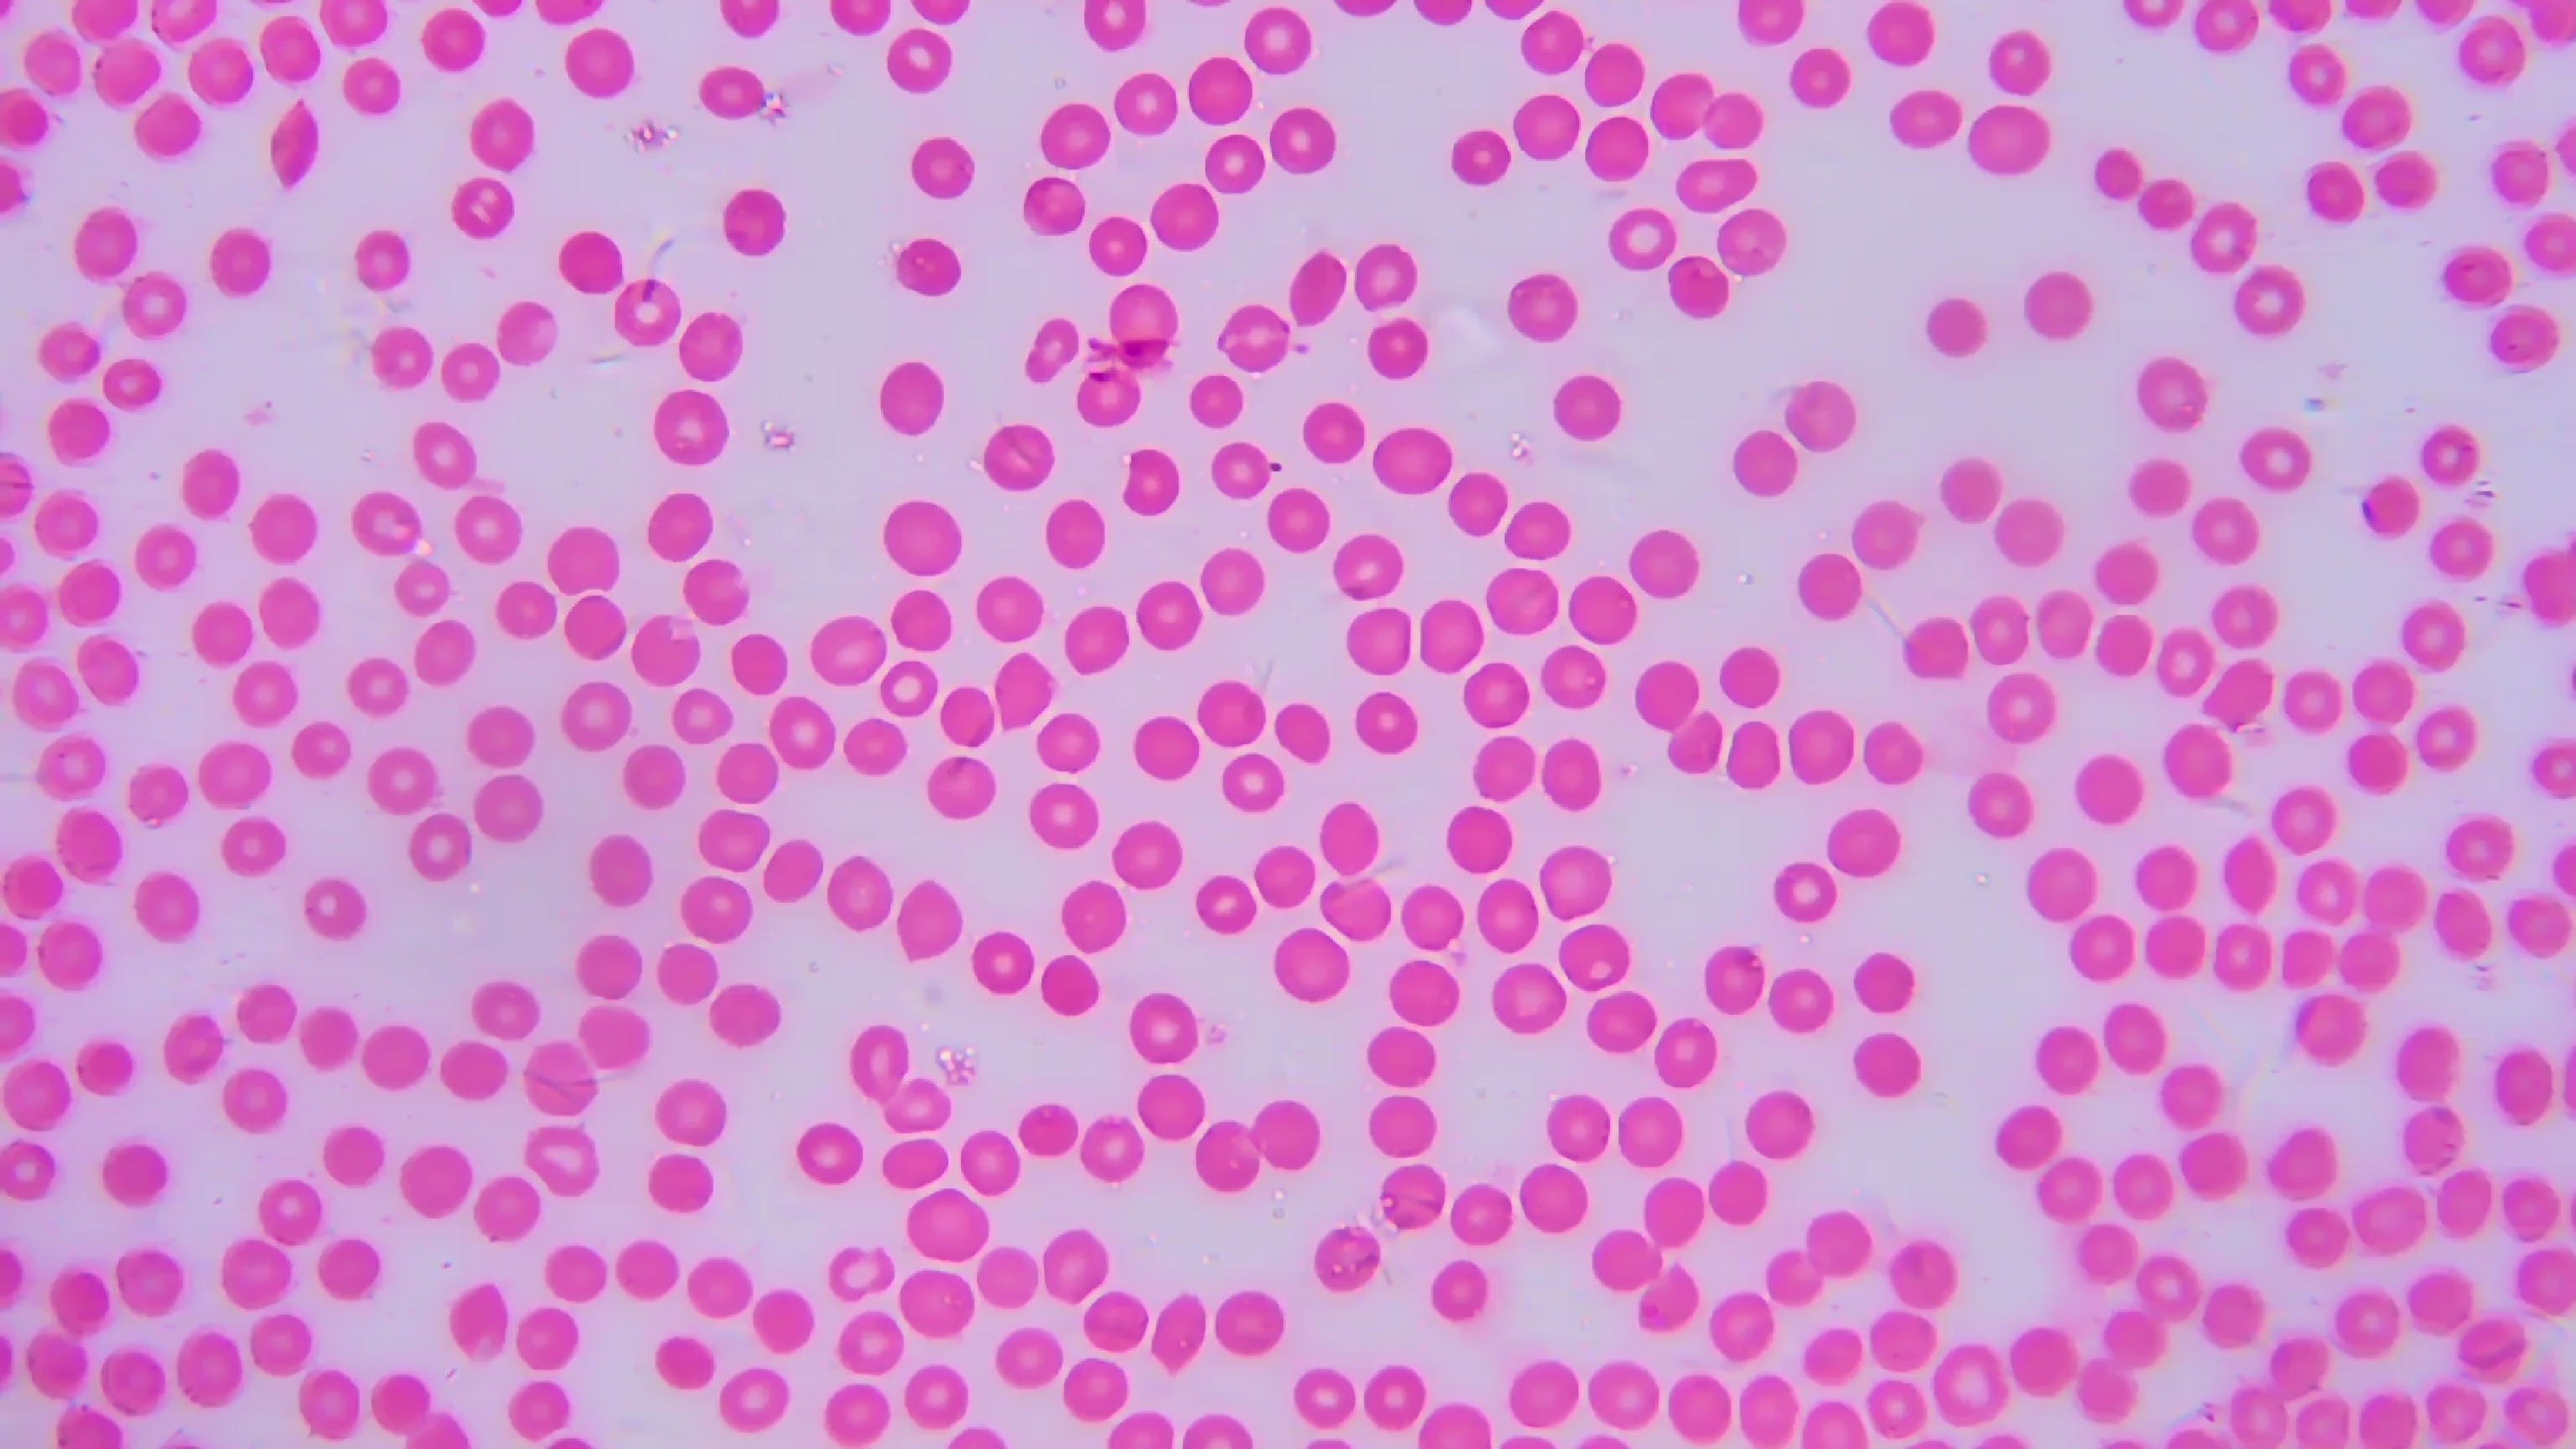
image

电子显微镜对生物的观察
视频建议到 B站观看,本页面效果不佳。
生物篇
人体
脊髓横切片。
观察到中央神经周围有数条神经发散。



心肌。
内有细胞残留。

神经末梢
树突清晰可见。

平滑肌


血液涂片
永久装片:观察到红细胞中间较薄,边缘厚。
自身血液:

黑框内有一个白细胞。

这是未凝固的血液在显微镜下流动。
小鱼
小鱼的主动脉。

小鱼的心脏跳动。
微生物篇
某黄色小虫,大概 \(100μm \times 400μm\) 的样子。


一只正在觅食不知名微生物。
植物篇
水绵
在 \(720\) 倍下 观察到水绵断口处,表现出水绵内部的叶绿体被透明的细胞壁包裹。

不断放大至 \(18000\) 倍,观察到水绵内部的叶绿体成雪花状螺旋排列。



在 \(18000\) 倍下,是可以看见很多生命体在水绵内部运动的。
某陆生植物
导管于筛管
根中有两条疏导管道。


根
根毛

根冠

茎横切
发现含有叶绿体的细胞成条状于茎内。

其叶绿体呈斑点状附着于细胞的细胞壁上。

叶片主叶脉
观察到其中央有一根运输管道(不清楚是导管,筛管)。


放大至 \(18000\) 倍,发现其完全不含叶绿体。

气孔
图中,半圆形的保卫细胞吸水,气孔处于张开状态。

气孔的面积较小,大概只有 \(123μm \times 127μm\) 左右。


浙公网安备 33010602011771号